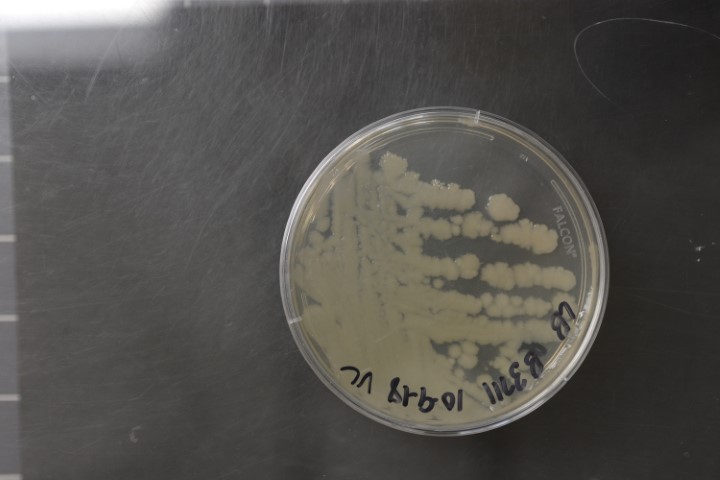

Bacillus cereus
NRRL B-3711(Type Strain)
Accession numbers in other collections:ATCC 14579=BCRC 10603=CCM 2010=CCUG 7414=CECT 148=CIP 66.24=DSM 31=IAM 12605=IAM 14174=IFO 15305=JCM 2152=KCTC 3624=LMG 6923=NBRC 15305=NCFB 1771=NCIB 9373=NCTC 2599=VKM B-504.
Source:ATCC<-Gordon,R.E.
Growth media:LB(number 44)
Optimum growth temperature:28C
Strain images:
NRRL_B-3711_44.JPG

Comments:1.Complete genome sequence available in GenBank(NC_004722)2.Produces restriction endonuclease Bce14579I